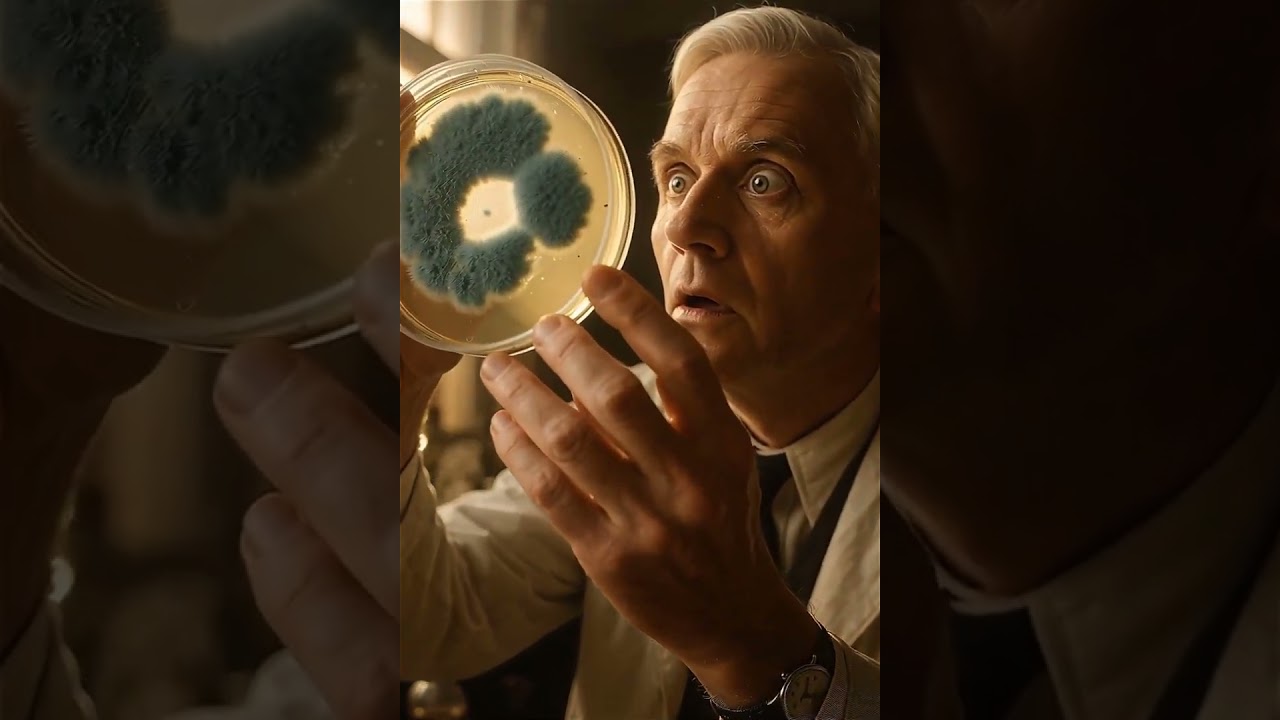
Alexander Flaming partì in vacanza

Il progetto
Canto i Fatti è nato come un esperimento e si è trasformato in un progetto: raccontiamo storia, scienza, letteratura e molto altro attraverso canzoni brevi e immagini create con l’intelligenza artificiale, per rendere lo studio un’esperienza che resta impressa. Non inseguamo tendenze o numeri: puntiamo su contenuti utili, chiari e piacevoli da riascoltare.
La nostra formula combina scrittura umana, coinvolgente, precisa e con un tocco di leggerezza, con strumenti di AI per musica, voce e immagini. Un equilibrio che ci consente di lavorare in modo rapido senza rinunciare alla qualità.
- Accessibilità: imparare attraverso suoni e immagini facilita memoria e comprensione.
- Qualità narrativa: testi orecchiabili, simbolismi e riferimenti culturali pensati per chi ama approfondire.
- Impatto reale: risorse utili per studenti, insegnanti e curiosi di ogni età.
Il progetto cresce passo dopo passo, aprendosi a nuove collaborazioni in ambito culturale ed educativo. Se una canzone riesce a far nascere curiosità, per noi è già un successo.
Chi siamo
Siamo un piccolo team con competenze complementari, unito dalla curiosità e dalla passione per le nuove tecnologie. Lavoriamo su un flusso semplice ma rigoroso: ideazione e scrittura del testo, direzione creativa, generazione musicale e visiva con strumenti AI, selezione dei risultati migliori e montaggio finale.
Usiamo piattaforme come Suno (voce e parti musicali), modelli di generazione immagini e sistemi video (es. Veo/Sora e alternative open source). Le macchine aiutano, ma la differenza la fa la supervisione umana: ritmo, tono, riferimenti e coerenza visiva nascono da scelte editoriali precise.
In poche settimane abbiamo visto crescere una community attiva: docenti che usano i nostri contenuti in classe, richieste di collaborazione, perfino inviti a esibirci per il valore divulgativo dei brani. Restiamo con i piedi per terra: studiamo, miglioriamo e portiamo cultura attraverso la musica e l’AI, lasciando al progetto la libertà di evolvere.
Contatti
Per collaborazioni e informazioni: [email protected]